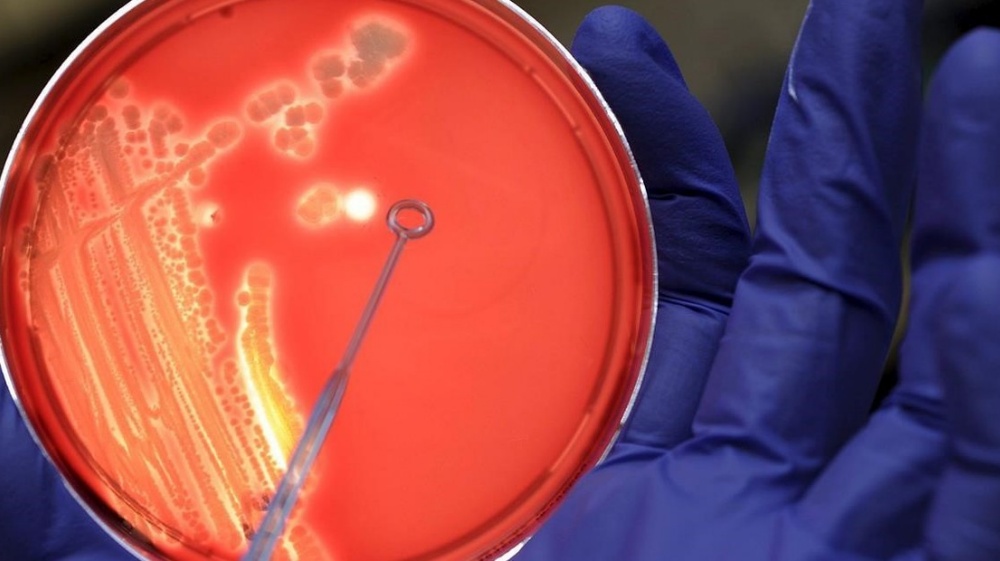

Fuerte remarcación de precios en supermercados: hay subas de hasta el 50%
En medio de la transición presidencial, mayoristas y proveedores anunciaron aumentos de precios, lo que impactó directamente este martes.
En medio de la transición presidencial entre Alberto Fernández y Javier Milei, y tras el feriado, los mercados volvieron a operar con una alta volatilidad del dólar blue, lo que se traduce en una fuerte remarcación de precios que rondan el 50%.
"Operadores financieros y agentes económicos están remarcando precios con miras a una fuerte devaluación. La Secretaría de Comercio dice que nada justifica este aumento de precios, que en algunos casos han llegado a las góndolas con subas de hasta el 45%", explicó la periodista de C5N Rosalía Constantino.
Y agregó que ambos equipos económicos "están negociando para que la transición sea lo más ordenada posible y no refleje esta suba de precios, al menos de acá al 10" de diciembre, cuando el presidente electo asuma.
Este martes, el dólar blue superó los $1000 este martes y esa incertidumbre se reflejó en las nuevas listas de precios que los comerciantes recibieron en las últimas horas.
En este contexto, una almacenera de Almagro en diálogo con C5N comentó que los proveedores anunciaron aumentos de entre un 40% y 50% respecto a los precios en góndola de la semana pasada, y cuestionó: "O sea, la mercadería que vamos a comprar al mayorista está al mismo precio que la que estamos vendiendo ahora. Para nosotros es muy engorroso, ¿cómo vendemos el producto?".
Ejemplo un paquete de fideos de primera marca "la semana pasada estaba a $1100. Si voy a comprarlo ahora, lo compro a $1200 y lo tengo que vender a $1500", explicó.